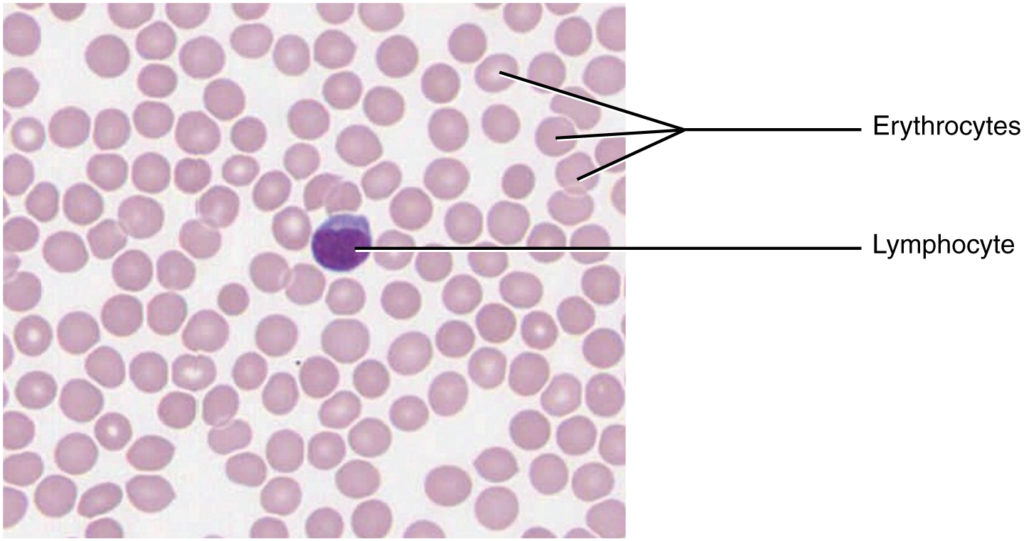
Blood: A Fluid Connective Tissue

3. Connective Tissue Supports and Protects
Functions of Connective Tissues
Connective tissues perform many functions in the body, most importantly, they support and connect other tissues: from the connective tissue sheath that surrounds a muscle, to the tendons that attach muscles to bones, and to the skeleton that supports the positions of the body. Protection is another major function of connective tissue, in the form of fibrous capsules and bones that protect delicate organs. Specialized cells in connective tissue defend the body from microorganisms that enter the body. Transport of gases, nutrients, waste, and chemical messengers is ensured by specialized fluid connective tissues, such as blood and lymph. Adipose cells store surplus energy in the form of fat and contribute to the thermal insulation of the body.
Embryonic Connective Tissue
All connective tissues derive from the mesodermal layer of the embryo (see Figure 2.2). The first connective tissue to develop in the embryo is mesenchyme, the stem cell line from which all connective tissues are later derived. Clusters of mesenchymal cells are scattered throughout adult tissue and supply the cells needed for replacement and repair after a connective tissue injury. A second type of embryonic connective tissue forms in the umbilical cord, called mucous connective tissue or Wharton’s jelly. This tissue is no longer present after birth, leaving only scattered mesenchymal cells throughout the body.
Structural Elements of Connective Tissue
Connective tissues come in a vast variety of forms, yet they typically have in common three characteristic components: cells, large amounts of amorphous ground substance, and protein fibers. Unlike epithelial tissue, which is composed of cells closely packed together, cells of connective tissue are more widely dispersed within an extracellular matrix (ECM). The matrix plays a major role in the functioning of this tissue. The major component of the matrix is ground substance. This ground substance is usually a fluid, but it can also be mineralized and solid, as in bones. The amount and structure of each component correlates with the function of the tissue, from the rigid ground substance in bones supporting the body to the inclusion of specialized cells; for example, a phagocytic cell that engulfs pathogens and also rids tissue of cellular debris.
Cell Types
Each class of connective tissue is formed by fundamental cell types. The cells can be found in both an active form (suffix –blast), where they are dividing and secreting the components of ground substance, and an in-active form (suffix –cyte). The most abundant cell in connective tissue proper is the fibroblast. Polysaccharides and proteins secreted by fibroblasts combine with extra-cellular fluids to produce a viscous ground substance that, with embedded fibrous proteins and cells, forms the extra-cellular matrix. Chondroblasts and osteoblasts are the primary specialized cell type located in cartilage and bone, respectively.
Adipocytes are cells that store lipids as droplets that fill most of the cytoplasm. There are two basic types of adipocytes: white and brown. The brown adipocytes store lipids as many droplets, and have high metabolic activity. In contrast, white fat adipocytes store lipids as a single large drop and are metabolically less active. Their effectiveness at storing large amounts of fat is witnessed in obese individuals. The number and type of adipocytes depends on the tissue and location, and vary among individuals in the population.
The mesenchymal cell is a multipotent adult stem cell. These cells can differentiate into any type of connective tissue cells needed for repair and healing of damaged tissue.
The macrophage cell is a large cell derived from a monocyte, a type of blood cell, which enters the connective tissue matrix from the blood vessels. The macrophage cells are an essential component of the immune system, which is the body’s defense against potential pathogens and degraded host cells. When stimulated, macrophages release cytokines, small proteins that act as chemical messengers. Cytokines recruit other cells of the immune system to infected sites and stimulate their activities. Roaming, or free, macrophages move rapidly by amoeboid movement, engulfing infectious agents and cellular debris. In contrast, fixed macrophages are permanent residents of their tissues.
The mast cell, found in connective tissue proper, has many cytoplasmic granules. These granules contain the chemical signals histamine and heparin. When irritated or damaged, mast cells release histamine, an inflammatory mediator, which causes vasodilation and increased blood flow at a site of injury or infection, along with itching, swelling, and redness (in people with light skin), recognized as an allergic response. Mast cells are derived from hematopoietic stem cells and are part of the immune system.
Connective Tissue Fibers and Ground Substance
Three main types of fibers are secreted by fibroblasts: collagen fibers, elastic fibers, and reticular fibers. Collagen fiber is made from fibrous protein subunits linked together to form a long, straight fiber. Collagen fibers, while flexible, have great tensile strength, resist stretching, and give ligaments and tendons their characteristic resilience.
An elastic fiber contains the protein elastin along with lesser amounts of other proteins and glycoproteins. The main property of elastin is that after being stretched or compressed, it will return to its original shape. Elastic fibers are prominent in elastic tissues found in skin, the walls of large blood vessels, and in a few ligaments which support the spine.
A reticular fiber is formed from the same protein subunits as collagen fibers, however, these fibers remain narrow and are arranged in a branching network. They are found throughout the body, but are most abundant in the reticular tissue of soft organs, such as the liver and spleen, where they anchor and provide structural support to the parenchyma (the functional cells, blood vessels, and nerves of the organ).
All of these fiber types are embedded in ground substance. Secreted by fibroblasts, ground substance is made of polysaccharides, specifically hyaluronic acid, and proteins. These combine to form a proteoglycan with a protein core and polysaccharide branches. The proteoglycan attracts and traps available moisture forming the clear, viscous, colorless ground substance.
Classification of Connective Tissues
The three broad categories of connective tissue are classified according to the characteristics of their ground substance and the types of fibers found within the matrix (Table 4.1). Connective tissue proper includes loose connective tissue and dense connective tissue. Both tissues have a variety of cell types and protein fibers suspended in a viscous ground substance. Dense connective tissue is reinforced by bundles of fibers that provide tensile strength, elasticity, and protection. In loose connective tissue, the fibers are loosely organized, leaving large spaces in between. Supportive connective tissue—bone and cartilage—provide structure and strength to the body and protect soft tissues. A few distinct cell types and densely packed fibers in a matrix characterize these tissues. In bone, the matrix is rigid and described as calcified because of the deposited calcium salts. In fluid connective tissue, lymph and blood, various specialized cells circulate in a watery fluid containing salts, nutrients, and dissolved proteins.
| Connective tissue proper | Supportive connective tissue | Fluid connective tissue |
|---|---|---|
Loose connective tissue:
|
Cartilage:
|
Blood |
Dense connective tissue:
|
Bone:
|
Lymph |
Connective Tissue Proper
Fibroblasts are present in all connective tissue proper (Figure 3.1). Fibrocytes, adipocytes, and mesenchymal cells are fixed cells, which means they remain within the connective tissue. Other cells move in and out of the connective tissue in response to chemical signals. Macrophages, mast cells, lymphocytes, plasma cells, and phagocytic cells are found in connective tissue proper but are actually part of the immune system protecting the body.

Loose Connective Tissue
Loose connective tissue is found between many organs where it acts both to absorb shock and bind tissues together. It allows water, salts, and various nutrients to diffuse through to adjacent or imbedded cells and tissues.
Adipose tissue consists mostly of fat storage cells, with little extracellular matrix (Figure 3.2). A large number of capillaries allow rapid storage and mobilization of lipid molecules. White adipose tissue is most abundant. It can appear yellow and owes its color to carotene and related pigments from plant food. White fat contributes mostly to lipid storage and can serve as insulation from cold temperatures and mechanical injuries. White adipose tissue can be found protecting the kidneys, cushioning the back of the eye, within the abdomen, and in the hypodermis. Brown adipose tissue is more common in infants, hence the term “baby fat.” In adults, there is a reduced amount of brown fat and it is found mainly in the neck and clavicular regions of the body. The many mitochondria in the cytoplasm of brown adipose tissue help explain its efficiency at metabolizing stored fat. Brown adipose tissue is thermogenic, meaning that as it breaks down fats, it releases metabolic heat, rather than producing adenosine triphosphate (ATP), a key molecule used in metabolism.

Areolar tissue shows relatively little specialization and is the most widely distributed connective tissue in the body. It contains all the cell types and fibers previously described and is structured in an apparently random, web-like fashion. It fills the spaces between muscle fibers, surrounds blood and lymph vessels, and supports organs in the abdominal cavity. Areolar tissue underlies most epithelia and represents the connective tissue component of epithelial membranes.

Reticular tissue is a mesh-like, supportive framework for soft organs such as lymphatic tissue, the spleen, and the liver (Figure 3.3). The reticular fibers form the network onto which other cells attach. It derives its name from the Latin reticulus, which means “little net.”
Dense Connective Tissue
Dense connective tissue contains more collagen fibers than does loose connective tissue. As a consequence, it displays greater resistance to stretching and a higher tensile strength. There are three major categories of dense connective tissue: regular, irregular, and elastic. Dense regular connective tissue fibers are parallel to each other, enhancing tensile strength and resistance to stretching in the direction of the fiber orientations. Ligaments and tendons are mostly formed from dense regular connective tissue.
In dense irregular connective tissue, the arrangement of proteins fibers is irregular and lacks the uniformity seen in dense regular . This arrangement gives the tissue greater strength in all directions and less strength in any one particular direction. In some tissues, fibers crisscross and form a mesh. In other tissues, stretching in several directions is achieved by alternating layers where fibers run in the same orientation in each layer, and it is the layers themselves that are stacked at an angle. The dermis of the skin is an example of dense irregular connective tissue rich in collagen fibers.
Dense elastic tissue contains elastin fibers in addition to collagen fibers, which allows the tissue to return to its original length after stretching. Dense elastic tissues give arterial walls the strength and the ability to regain original shape after stretching (dense CT figure).

Disorders of the Connective Tissue: Tendinitis
Your opponent stands ready as you prepare to hit the serve, but you are confident that you will smash the ball past your opponent. As you toss the ball high in the air, a burning pain shoots across your wrist and you drop the tennis racket. That dull ache in the wrist that you ignored through the summer is now an unbearable pain. The game is over for now.
After examining your swollen wrist, the doctor in the emergency room announces that you have developed wrist tendinitis. She recommends icing the tender area, taking non-steroidal anti-inflammatory medication to ease the pain and to reduce swelling, and complete rest for a few weeks. She interrupts your protests that you cannot stop playing. She issues a stern warning about the risk of aggravating the condition and the possibility of surgery. She consoles you by mentioning that well known tennis players such as Venus and Serena Williams and Rafael Nadal have also suffered from tendinitis related injuries.
What is tendinitis and how did it happen? Tendinitis is the inflammation of a tendon, the thick band of fibrous connective tissue that attaches a muscle to a bone. The condition causes pain and tenderness in the area around a joint. Most often, the condition results from repetitive motions over time that strain the tendons needed to perform the tasks.
Persons whose jobs and hobbies involve performing the same movements over and over again are often at the greatest risk of tendinitis. You hear of tennis and golfer’s elbow, jumper’s knee, and swimmer’s shoulder. In all cases, overuse of the joint causes a microtrauma that initiates the inflammatory response. Tendinitis is routinely diagnosed through a clinical examination. In case of severe pain, X-rays can be examined to rule out the possibility of a bone injury. Severe cases of tendinitis can even tear loose a tendon. Surgical repair of a tendon is painful. Connective tissue in the tendon does not have abundant blood supply and heals slowly.
While older adults are at risk for tendinitis because the elasticity of tendon tissue decreases with age, active people of all ages can develop tendinitis. Young athletes, dancers, and computer operators; anyone who performs the same movements constantly is at risk for tendinitis. Although repetitive motions are unavoidable in many activities and may lead to tendinitis, precautions can be taken that can lessen the probability of developing tendinitis. For active individuals, stretches before exercising and cross training or changing exercises are recommended. For the passionate athlete, it may be time to take some lessons to improve technique. All of the preventive measures aim to increase the strength of the tendon and decrease the stress put on it. With proper rest and managed care, you will be back on the court to hit that slice-spin serve over the net.
Supportive Connective Tissues
Two major forms of supportive connective tissue, cartilage and bone, allow the body to maintain its posture and protect internal organs.
Cartilage
The distinctive appearance of cartilage is due to polysaccharides called chondroitin sulfates, which bind with ground substance proteins to form proteoglycans. Embedded within the cartilage matrix are chondrocytes, or cartilage cells, and the space they occupy are called lacunae (singular = lacuna). A layer of dense irregular connective tissue, the perichondrium, encapsulates the cartilage. Cartilaginous tissue is avascular, thus, all nutrients need to diffuse through the matrix to reach the chondrocytes. This is a factor contributing to the very slow healing of cartilaginous tissues.
The three main types of cartilage tissue are hyaline cartilage, fibrocartilage, and elastic cartilage (Figure 3.5). Hyaline cartilage, the most common type of cartilage in the body, consists of short and dispersed collagen fibers and contains large amounts of proteoglycans. Under the microscope, tissue samples appear clear. The surface of hyaline cartilage is smooth. Both strong and flexible, it is found in the rib cage and nose and covers bones where they meet to form moveable joints. It forms the template of the embryonic skeleton before bone formation. A plate of hyaline cartilage at the ends of bone allows continued growth until adulthood. Fibrocartilage is tough because it has thick bundles of collagen fibers dispersed through its matrix. The intervertebral discs are examples of fibrocartilage. Elastic cartilage contains elastic fibers as well as collagen and proteoglycans. This tissue provides support as well as elasticity. Tug gently at your ear lobes, and notice that the lobes return to their initial shape. The external ear contains elastic cartilage.

Bone
Bone is the hardest connective tissue. It provides protection to internal organs and supports the body. Bone’s rigid extracellular matrix contains mostly collagen fibers embedded in a mineralized ground substance containing hydroxyapatite, a form of calcium phosphate. Both components of the matrix, organic and inorganic, contribute to the unusual properties of bone. Without collagen, bones would be brittle and shatter easily. Without mineral crystals, bones would flex and provide little support. Osteoblasts are the active bone forming cells, producing the organic part of the extracellular matrix. The mature bone cells, osteocytes, are located within lacunae. Bone is a highly vascularized tissue. Unlike cartilage, bone tissue can recover from injuries in a relatively short time.
The histology of a cross sectional view of compact bone shows a typical arrangement of osteocytes in concentric circles around a central canal. This structural unit of compact bone is called the osteon. There is no such structural unit in cancellous bone, or spongy bone, which looks like a sponge under the microscope and contains empty spaces between trabeculae. It is lighter than compact bone and found in the interior of bones and at the end of long bones. Compact bone is solid and has greater structural strength.
Fluid Connective Tissue
Blood and lymph are fluid connective tissues. Cells circulate in a liquid extracellular matrix. The formed elements circulating in blood are all derived from hematopoietic stem cells located in bone marrow (Figure 3.6). Erythrocytes, red blood cells, transport oxygen and carbon dioxide. Leukocytes, white blood cells, are responsible for defending against potentially harmful microorganisms or molecules. Platelets are cell fragments involved in blood clotting. Some white blood cells have the ability to cross the endothelial layer that lines blood vessels and enter adjacent tissues. Nutrients, salts, and wastes are dissolved in the liquid matrix and transported through the body.
Lymph contains a liquid matrix and white blood cells. Lymphatic capillaries are highly permeable, allowing larger molecules and excess fluid from interstitial spaces to enter the lymphatic vessels. Lymph vessels return molecules and fluid to the venous blood that could not otherwise directly enter the bloodstream. In this way, specialized lymphatic capillaries transport absorbed fats away from the intestine and deliver these molecules to the blood.